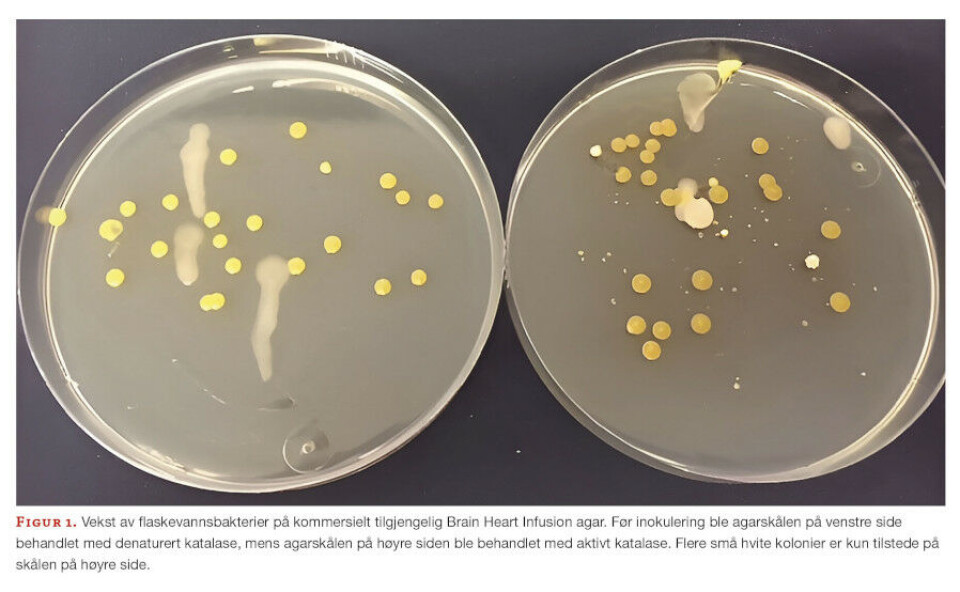

FAG Originalartikkel
Agar og fosfat - ikke så skjønn forening
Av COLIN CHARNOCK, professor i mikrobiologi ved Institutt for naturvitenskapelige helsefag (farmasi) ved OsloMet – storbyuniversitetet.
e-post: colin@oslomet.no
Agar og fosfat - ikke så skjønn forening – Kopi.pdf(217 KB)
De fleste bakterier som finnes i miljøet, ofte estimert til ≥ 99 % av alle cellene (1,2), antas å være vanskelig å dyrke eller delvis ikke dyrkbare. Det er mange grunner til dette og flere av disse er diskutert i vår oversiktsartikkel om temaet (3). Fenomenet begrenser vår adgang til viktige stoffer produsert av disse bakteriene.
Et slående eksempel er antibiotikumet teixobactin som ble isolert fra en hittil udyrket art, Eleftheria terrae, i 2015. Dette ble muliggjort ved å ta i bruk den såkalte iChip (4). Dette er et diffusjonskammer som legger til rette for dyrking av bakterier under forhold som er tilnærmet lik miljøet de stammer fra (3, 4). Alle tilgjengelige vekstmedier er mer eller mindre selektive for visse grupper av organismer. Noen nyere agarmedier unngår høye konsentrasjoner av næringsstoffer og satser heller på lavere og mer varierte blandinger av organiske forbindelser. Riktig bufring av vekstmediet, og inklusjon av agens som for eksempel pyruvat (antioksidant) og stivelse som fremmer vekst av stressede og skadede celler, representerer vesentlige forbedringer. Reasoner’s 2A agar (R2A) er et godt eksempel (5). Det har de siste årene også vært mange suksesser basert på utvikling av vekstmedier som er bedre etterligninger av naturlige miljøer (f.eks. jordagar), samt metodiske og teknologiske framskritt som «dilution-to-extinction» (6) og iCHIP (4).
I 2014 ble enda en faktor som begrenser veksten av bakterier på agarskåler beskrevet i publikasjonen A hidden pitfall in the preparation of agar media undermines microorganism cultivability (7). Publikasjon ble etterfulgt av en artikkel som så nærmere på årsaken til «den skjulte fallgruven» (8). Hva er så den skjulte fallgruven i tillaging av vekstmedier? Forfatterne viste at varmesterilisering av fosfat (en relativt vanlig buffer i agarmedier) sammen med agar førte til produksjon av hydrogenperoksid (H2O2) og muligens andre reaktive okysgenforbindelser (ROS). Materialet som forfatterne analyserte var miljøprøver hvor bakteriene ofte er saktevoksende og mer utsatt for oksidativt stress (7). Ved å autoklavere fosfat og agar separat ble det ikke dannet H2O2, og kimtallet ble inntil 20 ganger høyere (7,8). Det ble også funnet hittil ukultiverte bakterier (7). Tilsetting av katalase, som katalyserer spalting av H2O2 til vann og oksygen, i vekstmediet resulterte i tilsvarende kimtall, uavhengig av måten agaren ble tilberedt på. Med tanke på hovedmekanismen for dannelse av H2O2 ble maillardreaksjonene (MR), katalysert av fosfat, foreslått som mulig årsak (7,8). MR er en kompleks serie av kjemiske reaksjoner, som innledes mellom aminogrupper av organiske forbindelser (for eksempel proteiner) og karbonylgrupper på reduserende sukker. Etter hvert som MR skrider frem, dannes en blanding av dårlig karakteriserte produkter, inkludert giftige forbindelser som blant annet H2O2. Kawasaki og Kamagata (8) beskriver mulige mekanismer for dannelse av H2O2 hvor fosfat inngår som katalysator.
Disse studiene er imidlertid begrenset av at mediet var selvkomponert (de fleste laboratorier bruker ferdiglagde medier) og fosfatkonsentrasjon var noe høy. Videre ble ikke prøvemateriale med opphav hos mennesker eller dyr undersøkt.
Hensikten med denne studien er å gjenskape det opprinnelige arbeidet til Kawasaki og Kamagata. Videre er det undersøkt om to kommersielt tilgjengelige vekstmedier, med fosfatkonsentrasjoner tilnærmet lik de som tidligere er undersøkt (7,8), gir økt vekst av bakterier etter behandling med katalase. Humane så vel som miljøprøver ble testet for å øke relevansen for laboratorier som jobber med klinisk materiale.
Materiale og metode
Prøvemateriale
i) Seks «Flaskevann» (Nr. 1-6) uten tilsatt karbondioksid (klassifisert som enten kildevann eller naturlig mineralvann). Naturlig mineralvann og kildevann skal ikke desinfiseres eller utsettes for noe som kan endre det heterotrofe kimtallet.
ii) Springvann (OsloMet)
iii) Streptococcus pyogenes ATCC 19615
iv) Blandet prøve tatt ved svabring av innsiden av øyelokket, nesen, svelget og underarmen (av forfatter).
Katalaseløsning
Katalasepulver (C9322, Sigma-Aldrich/Merck) ble oppløst i 50 mM natriumfosfatbuffer (pH 7,0) ved 1mg/ml. Løsningen ble sterilfiltrert. Prøveporsjoner på 1ml ble denaturert ved oppvarming ved 70°C i 25 minutter. Aktivitet/fravær av aktivitet ble bekreftet ved å blande en dråpe av løsningen med en dråpe 10% H2O2. Prøveporsjoner på 35 µl (9 cm. agarskåler) eller 75 µl (14 cm. agarskåler) ble spredt på agaren før prøveinokulering.
Vekstmedier
Varmesterilisering for alle vekstmedier beskrevet under var ved 121°C i 20 minutter.
Medium 1: PT-medium (agar og fosfat varmebehandlet sammen) og PS-medium (agar og fosfat blandet etter varmesterilisering) ble fremstilt som beskrevet tidligere (7). Kort fortalt ble fosfat (20 mM) lagt til den agarholdige fraksjonen enten før varmesterilisering eller etter varmesterilisering når mediumkomponentene hadde nådd 50°C. Glukose ble også autoklavert separat og blandet med de andre komponentene etter varmesterilisering. Den endelige sammensetningen var 2,27 mM (NH4)2SO4, 0,2 mM MgSO4, 45 µM CaCl2, 15 g/L agar (214010, BactoTM BD), 10 mM KH2PO4, 10 mM Na2HPO4·12H2O, 0,1 g/L pepton (LP0085, Oxoid, Basingstoke), 0,1 g/L gjærekstrakt (7184A, Acumedia, Michigan) og 0,1 g/L D-glukose. Tilsvarende prosedyrer ble også utført med phytagel (P8169, Sigma-Aldrich/Merck) som geleringsmiddel istedenfor agar. Siden phytagel lett danner klumper ved kontakt med vann, ble pulveret langsomt tilsatt under omrøring. Sluttkonsentrasjon av phytagel i vekstmediene (PSphytagel og PTphytagel) var 10g/L (anbefalt konsentrasjon i produktdatabladet).
Medium 2 (fosfatfritt medium): 3 g/L gjærekstrakt (7184A, Acumedia), 6 g/L trypton (7351A, Acumedia), 15 g/L agar (BactoTM BD). Agaren ble enten varmebehandlet sammen med de andre innholdsstoffene eller separat før blanding. Mediene betegnes som henholdsvis «sterilisert sammen» eller «sterilisert separat».
Medium 3 (Hjernehjerteinfusjonsagar): BHIA, (CM1136B Oxoid): hjerneinfusjonstørrstoff, 12,5 g/L; biffhjerteinfusjonstørrstoff, 5 g/L; proteosepepton, 10 g/L; NaCl, 5 g/L; D-glukose, 2 g/L; Na2HPO4, 2,5 g/L (= 18 mM fosfat); agar, 10 g/L.
Medium 4 (Dikloran Rose-Bengal kloramfenikol (DRBC)- agarCM0727, Oxoid): pepton, 5 g/L; D-glukose, 10 g/L; KH2PO4, 1 g/L (= 7,4 mM fosfat); MgSO4, 0,5 g/L; dikloran, 0,002 g/L; Rose-bengal, 0,025 g/L; kloramfenikol, 0,1 g/L; agar, 15 g/L.
Forsøk med vannprøver
Vannprøvene (0,1 mL) ble spredt over agaren med vinkelbøyd stav på de ulike mediene, og inkubert ved 22 ± 2°C. Kolonier ble som regel telt etter to til fire uker, når antallet kolonier hadde stabilisert seg. Fordi mineralvann og kildevann inneholder en naturlig populasjon av mikrober vil det heterotrofe kimtallet og sammensetningen av mikrober som oftest endre seg dramatisk under lagring, spesielt etter åpning. Dermed ble ikke prøver tatt fra den samme flasken ved forskjellige tidspunkter, eller fra forskjellige flasker av samme merke, regnet som paralleller i statistisk sammenheng og testresultatene presenteres hver for seg.
Forsøk med gjærsopp og muggsopp
DRBC-kloramfenikol agar (medium 4) og BHIA (medium 3 tilsatt kloramfenikol) ble brukt. Etter behandling med katalase eller denaturert katalase ble agarskålene (14 cm.) plassert i vinduskarmen foran et åpent vindu (OsloMet campus) i 45 minutter. Antallet kolonier (luftbårne sopp) ble telt etter inkubering i fem døgn ved 22 ± 2°C.
Forsøk med S. pyogenes ATCC 19615
S. pyogenes ble dyrket aerobt på Colombia blodagar i 24 timer ved 36 ± 1°C. En stamløsning tilsvarende McFarland 0,5 i 0,85% NaCl ble brukt i forsøkene. To fortynningsserier ble laget fra stamkulturen og spredt (to paralleller per fortynning) på BHIA forbehandlet med enten katalase eller denaturert katalase. Agarskålene ble inkubert aerobt i 48 timer ved 36 ± 1°C. For å stresse cellene ble stamløsningen oppbevart ved 8°C i 24 timer, før en ny serie ble sådd ut.
Forsøk med kommensale bakterier (svabreprøver)
MSwabs (COPAN, US) ble brukt til å ta prøver av henholdsvis innsiden av øyelokket, svelget, nesen og underarmen (fra forfatteren). Prøvene ble slått sammen, fortynnet i 0,85% NaCl og sådd ut på BHIA forbehandlet med enten katalase eller denaturert katalase. En serie ble inkubert aerobt ved 36 ± 1°C i sjudøgn, mens en parallell serie ble inkubert anaerobt under samme forhold.
Kolonitelling og beregning
Kimtallet (antall kolonier pr mL, CFU/mL) ble beregnet med formelen nedenfor. Dersom to agarskåler fra samme fortynning ga mellom 25-250 kolonier ble gjennomsnittet brukt så lenge tallene ikke var forskjellig med mer enn 10 %. Hvis to påfølgende fortynninger ga kolonitall med 25-250 kolonier, ble følgende formel brukt.

• N = Antall kolonier per ml (CFU/mL)
• ∑ C = Summen av alle kolonier på alle agarskåler
• n1 = Antall skåler i første fortynning talt
• n2 = Antall skåler i andre fortynning talt
• d = Fortynning som de første tellingene ble oppnådd fra
16S rDNA sekvensering
Bakterier ble identifisert basert på Sanger-sekvensering av 16S rDNA-genet, nøyaktig som tidligere beskrevet (9).
Resultater
Kimtallet av vannprøver på medium 1 (PT- og PS-medium)
Tabell 1 viser resultater fra et utvalgt, representativt forsøk, samt antallet forsøksrunder. I samtlige tester var kimtallet på PT (medium 1, fosfat autoklavert sammen med andre innholdsstoffer) lavere enn på PS (medium 1, fosfat autoklavert separat fra andre innholdsstoffer).
Resultatene viser at varmesterilisering av agar sammen med fosfat (PT) har en betydelig og negativ innvirkning på kimtallet for alle vanntyper sammenlignet med PS. I noen forsøk ble agaren vasket flere ganger med vann før bruk i vekstmediene. Vask hadde liten eller ingen effekt på kimtallet: For flaskevann 1: PT-kimtallet var 5 % av PS-kimtallet (uvasket agar) mens med vasket agar var andelen 12 %. Tilsvarende tall for flaskevann 2 var henholdsvis 15 % og 13 %. Dette resultatet indikerer at eventuelle vannløselige kontaminanter i agarpulveret ikke kan forklare resultatene i tabell 1.

Tabell 2 viser at den veksthemmende effekten av å varmesterilisere fosfat sammen med agar også ble sett ved langt lavere fosfatkonsentrasjoner, men forskjellen mellom PT-kimtallet og PS-kimtallet var mindre med 5 mM fosfat enn med 20 mM fosfat for samtlige vanntyper. Relevant er også observasjonen at PS-kimtallet5mM ≥ PS-kimtallet20mM (tabell 2).

Dette funnet betyr at relativt høye fosfatkonsentrasjoner er i seg selv skadelig for miljøbakterier. Tolkning av resultatene gis med forbehold om at det kun ble gjennomført én testrunde per vanntype.
Kimtallet av vannprøver på medium 2 (fosfatfritt medium)
Forsøk med vekstmedium uten fosfat (medium 2) er vist i tabell 3.

Tabellen viser at måten fosfatfritt medium blir tilberedet på (agar tilsatt før eller etter varmebehandling av næringsgrunnlaget) er av liten eller ingen betydning for kimtallet. Det var derfor interessant at dersom agarskålene ble behandlet med katalase, ble det observert en økning i kimtallet relativt til kontrollen (tabell 4).

Det kan muligens forklares med innvirkning fra andre prosesser som danner ROS hvor fosfat ikke inngår. Økningen i kimtallet etter katalase-behandling kunne for begge vanntyper i stor grad tilskrives veksten av kolonityper som kun var synlige, eller til stede i langt høyere antall, på katalasebehandlede skåler (se tabell 4). Bakteriene ble identifisert basert på sekvensering av 16S rDNA-genet. Disse var en Ampullimonas-art (vanntype 3) og en Undibacterium-art (vanntype 4). Begge slekter er tidligere blitt funnet i drikkevann (10).
Bruk av phytagel som geleringsmiddel
For å undersøke om et annet geleringsmiddel (phytagel) enn agar resulterte i lavere kolonitall når det ble autoklavert sammen med fosfat, ble forsøket vist i tabell 1 gjentatt med både agar og phytagel som geleringsmiddel. Forsøket ble gjennomført to ganger med fire ulike vanntyper. Resultatene fra begge testrunder er vist i tabell 5.

Samtlige testresultater viser at også phytagel i kontakt med fosfat under varmesterilisering (PT-phytagel) førte til redusert kimtall sammenlignet med PS-phytagel, men at reduksjonen er noe mindre enn med agar. At PS-kimtallet er høyere enn PT-kimtallet er derfor ikke utelukkende et agar-relatert fenomen.
Forsøk med medium 3 (BHIA, fosfatholdig ferdigblandet agar)
Kimtallet på BHIA etter forbehandling med enten katalase eller denaturert katalase (kontroll) er vist i tabell 6.

Agarskåler som var forbehandlet med aktivt katalase ga langt høyere kimtall enn agarskåler behandlet med denaturert katalase. Flasker med vanntype 2 ble i alt testet mer enn ti ganger, og samtlige testresultater viste en økning i kimtall etter katalase-behandling. Testing av flaskevann 2 på BHIA behandlet med katalase, ga vekst av kolonityper som ikke var til stede på skåler behandlet med denaturert katalase. Bakteriene i en kolonitype tilhørte slekten Hydrogenophaga. Likedan ble vekst av en Variovorax-art observert på katalasebehandlede agarskåler inokulert med vanntype 1. Begge slekter er tidligere funnet i drikkevann (10).
Forsøk med BHIA og DRBC (luftbårne sopp)
Tabell 7 viser resultater av forsøk med DRBC ([fosfat] 7,4 mM) og BHIA-klormafenikol ([fosfat] 18 mM), gjennomført henholdsvis tre og to ganger med nye produksjonspartier av vekstmediene.

I noen tilfeller var kimtallet på agarskåler behandlet med katalase noe større enn på skåler behandlet med denaturert enzym, mens i andre tilfeller var det motsatt. Det ble ikke observert kolonityper som kun vokste med, eller i fravær av, katalasebehandling. Kolonier var i hovedsak typiske muggsopper, men noen få gjærsopper ble også funnet. Tolkning av resultatene gis med forbehold om at det kun ble gjennomført to (BHIA) og tre (DRBC) testrunder.
Vekst av S. pyogenes ATCC 19615 på BHIA
Streptococcus pyogenes (Gruppe A-streptokokker) er en hyppig årsak til tonsillitt, bihulebetennelse og en rekke andre infeksjonstyper. Tabell 8 viser resultatet når en McFarland 0,5 suspensjon ble sådd ut på BHIA etter forbehandling av agarskålene med katalase/denaturert katalase.

Det ble sådd ut to parallelle skåler fra to fortynningsserier. Kulturen etter utsåing ble oppbevart i 24 timer ved 8°C for å stresse cellene, og deretter testet på nytt. I forsøksserie 1 ble det telt et noe høyere antall kolonier på agarskålene behandlet med katalase, mens i serie 2 ble den motsatt tendensen registrert. Forskjellene betraktes som små. Oppbevaring av cellesuspensjon ved 8°C i 0,85% NaCl i 24 timer (stressende forhold) reduserte kimtallet i forhold til ferskt tillaget kultur, men denne behandlingen gjorde ikke cellene relativt sett mer følsomme for eventuelt H2O2 eller andre ROS i agarmediet.
Vekst av kommensale bakterier på BHIA
Tabell 9 viser resultatene fra to uavhengige analyseserier med nye prøver og nye agarmedier.
Alle tre behandlingstyper (uten katalase, denaturert katalase og aktiv katalase) ga lignende kimtall under samme forhold (aerob eller anaerob dyrking). Det ble heller ikke observert kolonityper som kun var til stede, eller til stede i høyere antall, på agarskåler behandlet med katalase.

Diskusjon
Tross store framskritt i molekylærbiologibasert identifikasjon, forblir dyrkning av bakterier grunnpilaren i mye av rutinemessig mikrobiologisk diagnostikk, samt i kvalitetskontroll av næringsmidler, farmasøytiske preparater og luftprøver. Imidlertid har dyrking av bakterier en iboende svakhet ved at kun en liten andel av bakteriene i komplekse miljøer som jord og vann lar seg dyrke i renkultur på syntetiske laboratoriemedier. Produksjon av H2O2 og andre ROS under varmesterilisering av agar i nærvær av fosfat er utpekt som en vesentlig årsak til at få miljøbakterier vokser på næringsagar (7). Det har ikke tidligere blitt undersøkt om dette fenomenet også oppstår når kommersielt tilgjengelige medier som inneholder betydelige fosfatkonsentrasjoner steriliseres ved autoklavering. Vi vet også lite om hvorvidt bakterier med opphav i klinisk materiale påvirkes av eventuell produksjon av ROS under varmesterilisering.
Denne studien har sett nærmere på disse punktene. Tanaka et al. (7) beskriver et 3-komponentmedium hvor fosfatdelen og agardelen kan autoklaveres hver for seg (PS-medium) eller sammen (PT-medium). I herværende studie ble PS og PT produsert og testet mot «miljøbakteriene» i norskprodusert naturlig mineralvann og kildevann. Resultatene gitt i tabell 1 viser at også for «vannbakterier» er PS-kimtallet større enn PT-kimtallet, og det var flere tilfeller hvor distinkte kolonimorfologier kun ble observert på PS.
Resultatene bekrefter og utvider tidligere funn (7,8). Når fosfatinnholdet i PS/PT ble redusert fra 20 mM til 5 mM forble PS-kimtallet større enn PT-kimtallet, men forskjellen var mindre (tabell 2). Kawasaki og Kamagata (8) fant at når lengden på varmesterilisering ble økt fra 15 minutter til 90 minutter i nærvær av 20 mM fosfat ble det en kvadrupling i konsentrasjonen av H2O2. Ved lave fosfatkonsentrasjoner (~ 3 mM) uteble økningen. Selv om en varmesteriliseringsperiode på 90 minutter ikke er vanlig praksis, er det flere kjente vekstmedier som inneholder langt mer enn 3 mM fosfat (for eksempel BHIA, se under). Det anbefales derfor å utvise forsiktighet ved tilberedning av varmesteriliserte fosfatholdige medier.
Det ble også observert at PS-kimtallet5mM > PS-kimtallet20mM (tabell 2) og dermed at 20 mM fosfat i seg selv er vekstbegrensende for miljøbakterier. Et vekstmedium uten tilsatt fosfat (medium 2) ble komponert og testet. Resultatene i tabell 3 viser at varmesterilisering av agaren, enten sammen med eller adskilt fra næringsstoffene, har samme effekt på kimtallet. Disse forsøkene (tabell 2 og 3) indikerer at fosfatinnholdet er den mest vesentlige forklaring på PS-kimtallet > PT-kimtallet. Det var derfor interessant at agarskålene (uten tilsatt fosfat, medium 2) som ble behandlet med katalase før prøveutsåing, ga både flere - og flere forskjellige kolonier - enn skålene som ble behandlet med denaturert katalase (tabell 4). Blant kolonitypene som kun vokste (eller vokste i større antall) etter katalasebehandling, var en Ampullimonas-art (flaskevann 3) og en Undibacterium-art (flaskevann 4). En mulig forklaring på dette er at katalase fjerner en eller flere toksiske forbindelser som oppstår under varmesterilisering, hvorav dannelsen synes å være uavhengig av fosfat (se diskusjon under). Det kan ikke uten videre utelukkes at det var fosfatrester i medium 2, men om så forventes konsentrasjonen å være svært lav. Når pyruvat, som også effektivt fjerner H2O2 (8), ble brukt istedenfor katalase, ble en lignende, men noe mindre, effekt målt (resultater ikke vist). Det er blitt foreslått av andre (8) at katalase potensielt kan fjerne en rekke andre toksiske forbindelser enn kun H2O2 (for eksempel formaldehyd, alkoholer) som kan oppstå under varmesterilisering. For å undersøke nærmere om agarkomponenten var nødvendig for utfallet PS-kimtallet > PT-kimtallet, ble PS og PT laget med et alternativt geleringsmiddel, phytagel. Resultatene i tabell 5 viser at også varmesterilisering av phytagel sammen med fosfat (PTphytagel) fører til en relativ reduksjon i kimtall sammenlignet med PSphytagel. Dermed oppstår ikke PS-kimtallet > PT-kimtallet kun i nærvær av agarpulver. Kawasaki og Kamagata (7) rapporterer også produksjon av H2O2 ved bruk av phytagel. Det konkluderes med at erstatning av agar med phytagel som geleringsmiddel ikke løser PS-kimtallet > PT-kimtallet-problemet, og at PS-kimtallet > PT-kimtallet ikke utelukkende forbindes med fosfat.
De mye brukte, og kommersielt tilgjengelige, vekstmediene BHIA og DRBC inneholder henholdsvis 18 mM og 7,4 mM fosfat. For å undersøke om det oppsto toksiske forbindelser under varmesterilisering som kunne fjernes med katalase, ble agarskålene behandlet med aktivt eller denaturert katalase. I forsøk med flaskevann (tabell 6) viser katalase-behandling av BHIA en vesentlig økning i kimtallet sammenliknet med bruk av denaturert katalase tilsvarende forsøk med ikke-kommersielt tilgjengelige agarer. Derimot hadde katalase lite å si for veksten av luftbårne fungi (tabell 7). Om ROS-dannelse er årsaken til begrenset vekst av miljøbakterier, er luftbårne fungi langt mindre påvirket av dette. DRBC brukes i kvalitetskontroll av luften i miljøer hvor blant annet legemidler eller næringsmidler produseres. Det konkluderes med at her er det liten eller ingen gevinst å få ved å inkludere et trinn med katalasebehandling av DRBC (eller BHIA-kloramfenikol) før bruk. Det bør presiseres at næringsrike medier som BHIA ikke vil være førstevalg for testing av vannprøver. R2A (se innledning) som også inneholder pyruvat gir langt høyere kimtall enn næringsrike medier (5), som heller brukes i undersøkelse av klinisk materiale. Dermed ble det gjort forsøk for å undersøke om den viktige patogene bakterien S. pyogenes og kommensale bakterier påvirkes av katalasebehandling av BHIA.
Miljøbakterier er typisk saktevoksende, aerobe bakterier og kan være mer utsatt for oksidativt stress enn hurtigvoksende arter (7). I tillegg til å være potensielt sykdomsframkallende, ble S. pyogenes valgt for testing også fordi medlemmer av slekten mangler katalase (de har andre mekanismer for å fjerne ROS). Det ble også undersøkt om antatt cellulære stress (kulde uten næring) hadde effekt. Resultatene er vist i tabell 8. Det ble ikke registrert gjennomgående og vesentlig forskjeller i kimtallet (friske og stressede celler) som kan knyttes til bruk av katalase. For å utvide omfanget av analysen fra en enkeltstående art til en populasjonsstudie, ble en blandet prøve av øyelokkets, svelgets, nesens og underarmens kommensale bakterier testet. En serie med agarskåler ble inkubert aerobt og en serie ble inkubert anaerobt. Begrenset adgang til atmosfærisk oksygen forventes å påvirke konsentrasjon så vel som type ROS produsert. Igjen ble det ikke observert vesentlig effekt av katalasebehandling på kimtallet, og det var ingen kolonityper som kunne forbindes eksklusivt med katalase-behandlingen (tabell 9). Disse to testene alene kan selvfølgelig ikke anses å være helt representative for alt klinisk materiale, men indikerer at ROS-dannelse på standard laboratoriemedier ikke begrenser veksten av hurtigvoksende humane bakterier i like stor grad som «vannbakterier».
Konklusjon
Denne studien gir holdepunkter for at det dannes forbindelser som er toksiske for «vannbakterier» under varmesterilisering av vekstmedier, spesielt når relativt høye fosfatkonsentrasjoner (minst 5 mM) autoklaveres med agar eller phytagel. Disse prosessene er derimot av minimal betydning når næringsrike, fosfatholdige medier, som for eksempel BHIA og DRBC, brukes til dyrking av humane bakterier eller luftbårne sopp.
Takk til
Noen av resultatene er hentet fra bacheloroppgaven til Nonni Gravdahl, Julia Kyunghee Kang, Berina Qoragllu og Hege Ramstad (Avd. for farmasi, OsloMet, 2016).
Takk til Hilde Kjølberg og Ane Gedde-Dahl for kommentarer til forbedring av manuskriptet.